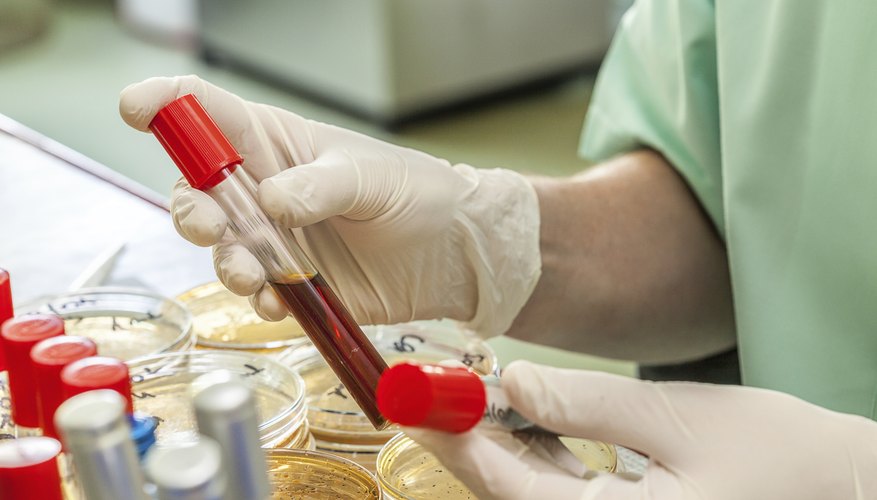
У Британії стартують масштабні тестування на рак за зразком крові

У Британії цього тижня стартує масштабне тестування на рак за участю 140 тисяч добровольців у віці від 50 до 77 років. Учасники здаватимуть зразки крові, а через 1-2 роки зразки візьмуть повторно.
Як пише The Guardian, новий тест дозволить визначити понад 50 типів пухлин, зокрема рак легенів, кишківника та підшлункової залози, яєчників, печінки, стравоходу, шийки матки, передміхурової залози, а також деякі типи онкогематологічних захворювань по крові на ранній стадії.
За словами представника компанії Grail, тест під назвою Galleri дозволяє виявляти зміни ДНК на ранніх стадіях захворювання на рак. Це дасть можливість виявити новоутворення до появи симптомів у людини і значно підвищити ефективність лікування.
“Тест може стати проривом для ранньої діагностики раку, і ми раді очолити це важливе дослідження, — зазначив професор онкології Королівського коледжу Лондона Пітер Сасіені, який є керівником програми досліджень. — Нам необхідно ретельно вивчити тест Galleri, щоб з’ясувати, чи може він значно знизити кількість ракових захворювань, діагностованих на пізній стадії”.
Участь у випробуваннях візьмуть випадкові люди, без підозр на рак. Таким чином науковці планують оцінити ефективність тесту в якості простого скринінгового методу. Тест з аналізу крові визначає фрагменти ДНК, які виділяються пухлиною в кровотік.
Такий підхід дозволяє ідентифікувати рак на ранній стадії, коли клінічні симптоми ще не проявляються.
Перші результати випробувань планують отримати до 2023 року. Якщо вони будуть успішними, то в період з 2024 по 2025 роки до участі запросять ще близько мільйона учасників.